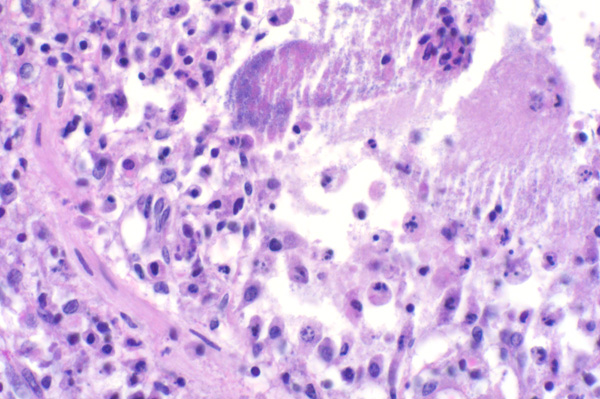

| 40x | Hematoxylin and Eosin | ||||
| Close Window | Macro View | Show Help | Back | |
|
Sloughed epithelial cells, degenerate neutrophils, necrotic debris and a bacterial colony (see help) fill this bronchiole.
|
||||

|
||||
| Return | ||||
|
Sloughed epithelial cells, degenerate neutrophils, necrotic debris and a bacterial colony (see help) fill this bronchiole.
|
||||